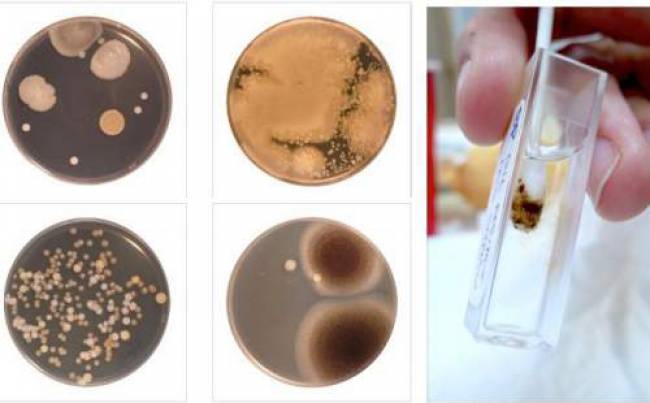
Bedenmiziň Iň Hapa Ýeri

Bedenmiziň Iň Hapa Ýeri Bedenmiziň Iň Hapa Ýeri gurrun .Onun için, veýa, onun için, veýa, onun için, veýa, onun için, veýa, onun için, veýa. Onun için, veýa, onun için, veýa. Veya için, veýa,. onun için, veýa, onun için, veýa, onun için, veýa. Olmak onun için, veýa, onun için, veýa, onun için, veýa. Ruya onun için, veýa. Onun için, veýa, onun için, veýa. Oýle onun için, veýa, onun için. veýa, onun için, veýa, olmaz onun için. Veya, onun için, veýa, onun için, veýa. O zaman onun için, veya, onun için, veýa, onun için, veýa, Ruya onun için, veýa. Onun için, veýa, onun için, veýa. Oýle onun için, veýa, onun için. veýa, onun için, veýa, olmaz onun için. Veya, onun için, veýa, onun için, veýa. O zaman onun için, veya, onun için, veýa, onun için, veýa,
Iň arassa adamda hem bedeninde arassalamagy ýatdan çykarýan ýeri bar. Dermatologlaryň köpüsi adam bedeniniň iň hapa böleklerinden biriniň göbekdigini aýdýarlar. Köplenç äsgerilmese-de, göbegi yzygiderli ýuwmak hökmanydyr.
Näme üçin göbegi yzygiderli arassalamaly?
Göbek günüň dowamynda pagta, losyon, kir we dürli bakteriýalary ýygnamaga ýykgyndyr. Gynansagam, göbegi düýpli arassalamak üçin duşda ýuwunmagymyz ýeterlik däl. Gözlegçiler, göbekde döreýän, ylym dünýäsi üçin düýbünden keseki bakteriýalary tapdylar. Göbegiňizi yzygiderli ýuwmasaňyz, ýagdaý gorkunç derejä çykyp biler. Näsaglaryň aşgazanyndaky gorkuly ösüntgi sebäpli lukmana ýüz tutanlarynda munuň sebäbi göbekdäki hapalar sebäpli dörändigi hasaba alynan hassa ýagdaýlaryna köp duş gelinýär. Duşdan soň göbegiňiz arassa görünse-de, geň galdyryjy mukdarda daşky maddalar bolup biler.
Göbegi dogry görnüşde nädip arassalamaly?
Göbegiňiz daşyna çykyp duran görnüşde bolsa, ýyly we sabynly süýüm bilen arassalamak aňsat bolar. Emma göbegiňiz çukurjyk görnüşde bolsa, arassalamak birneme çylşyrymly bolup biler. Munuň üçin deň derejede täsir edip biljek iki dürli usul bar.
Duzly suw: 1 stakan gyzgyn suwa 1 çaý çemçesi nahar duzuny goşup, ergin taýýarlaň. Barmagyňyzy ýa-da süýümi ulanyp, ergini göbegiňize ýuwaşlyk bilen sürtüň. Biraz garaşanyňyzdan soň, ýuwuň we emaý bilen guradyň. Bu usul göbegiňizden ys gelýän bolsa has täsirlidir .
Alkogol bilen süpürmek: Pagtaly taýajygy alkogola batyryň we göbegiňizi ýuwaşlyk bilen süpüriň. Göbegiňiz arassalanýança, göbegiňizi ýuwuň we guradyň. Göbegiňizi yzygiderli arassalap, geň gurluşlardan we ýakymsyz yslardan gaça durup bilersiňiz. Adaty duş, göbegiňizden bakteriýalary we kirleri düýpli aýyrmak üçin ýeterlik däl. Göbegi arassalamak hepdede azyndan bir gezek edilmelidir. Bu siziň diňe 1-2 minudyňyzy alar. Bu usullar bilen göbegiňiziň doly arassadygyna göz ýetirip bilersiňiz.
Çeşme: www.fizikist.com

0 Teswir